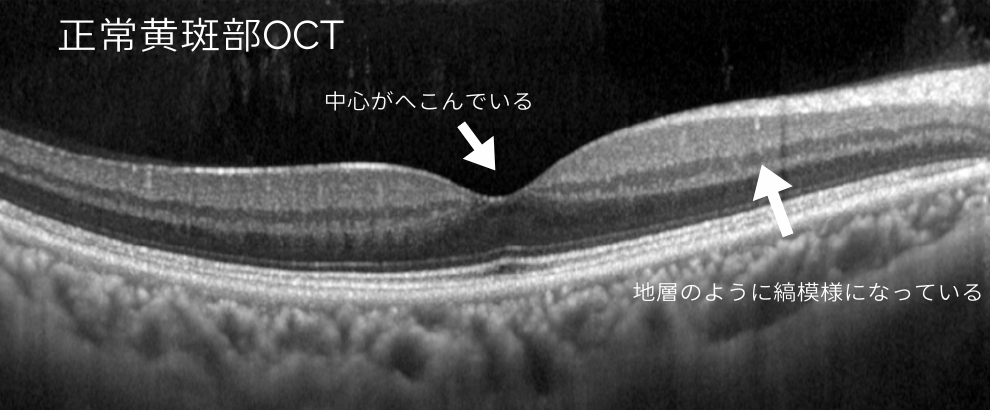
正常の黄斑部のOCT画像
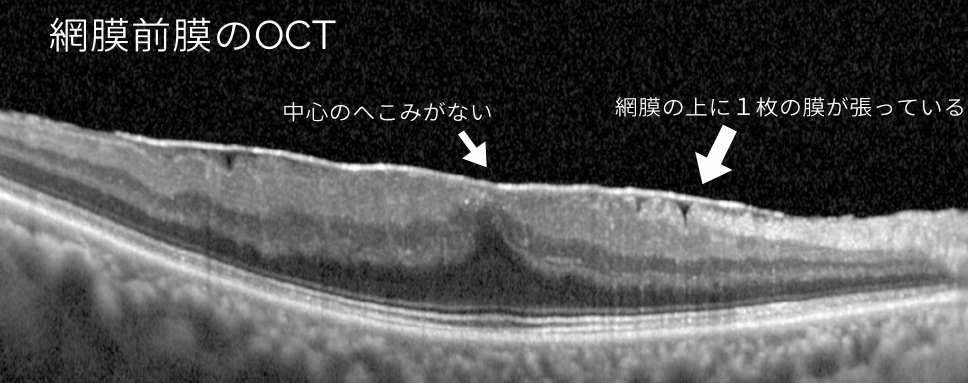
網膜前膜のOCT画像

患者さんが“なんとなくわからないまま受けている検査No.1”が、このOCT(光干渉断層計)検査です。
診察のときに「ではOCT撮りましょう」と言われて撮影したものの、
どんな検査で、何がわかるのかを詳しく聞いたことがない方も多いのではないでしょうか?
この記事では、OCT検査で何が見えるのか、どんな病気に役立つのかを、
わかりやすく解説していきます。
関連記事:【白内障と診断された方へ、原因・治療・費用についてまとめました。】
OCT検査とは?


OCT(Optical Coherence Tomography:光干渉断層計)とは、
目の奥の網膜や視神経の状態を、断面画像として見る検査です。
レントゲンやCTのように、光を使って目の内部を立体的に観察できるため、
肉眼では見えないごく小さな異常を早期に見つけることができます。
この検査は痛みもなく、固視灯の光を数秒見つめるだけで終わります。



レンズを使って医師が直接眼底(網膜)を見ただけではわからないような微細な変化も、この検査で測定することができるよ!!



こんな素晴らしい機械を発明した人がすごすぎるぅ
どんなときに行う検査?


OCTは、以下のような病気や状態を調べるときに行われます。
- 緑内障の早期発見と経過観察
→ 視神経の厚みや構造を測ることで、変化をいち早くキャッチできます。視野検査よりも早期に変化が出るといわれています。 - 加齢黄斑変性や網膜前膜などの網膜疾患
→ 網膜の中心部(黄斑)のむくみや膜の変化を観察。手術や注射での治療が必要かどうか判断するうえで最も重要。 - 糖尿病網膜症
→ 出血や浮腫の程度を詳しく確認。 - 視神経のむくみや萎縮の評価
OCTは、「目の健康診断」的な役割も果たしており、定期検査として行われることもあります。
関連記事:【眼科疾患を種類ごとに解説しています。】
検査の流れ


- 検査室で椅子に座り、あごとおでこを台にのせます。
- 正面に見える赤い光やマークをじっと見つめます。
- 数秒間で撮影完了。痛みはまったくありません。
基本的には無散瞳で検査を受けることができます。



眼圧検査や視野検査のように患者さんに嫌がられたことはないくらい、
負担の少ない検査です!
関連記事:【風が目に当たる定番の検査を詳しく解説しています↓↓】


OCTでわかること


OCTで得られる画像は、網膜や視神経の“断層図”。
これにより、次のような情報がわかります。
- 網膜の厚み(むくみや薄くなっていないか)
- 視神経の萎縮やむくみ
- 網膜下の膜、出血、浮腫などの異常
通常の眼底写真では「表面しか見えない」のに対し、OCTは内部構造まで見えるのが最大の特徴です。
OCTアンギオグラフィ(OCTA)は、OCTの技術を使って網膜の血流を画像化する検査です。
造影剤を使わないため、腎機能が悪い方や造影剤アレルギーのある方でも安心して受けられます。
目の奥の血管の流れを可視化でき、血管の漏れている部位や血液が流れていないところの特定などの詳しい診断に役立ちます。
通常のOCTより少し時間がかかりますが、痛みはなく安全に行える検査です。
OCT画像紹介
実際のOCT画像とその見方の一例をご紹介します。
大きく分けて、黄斑部を撮影する取り方と視神経を撮影する取り方があります。
黄斑部のOCT画像
加齢黄斑変性や黄斑前膜、糖尿病網膜症、網膜静脈分枝閉塞症などのものを見る中心の障害(黄斑部障害)に対して行います。
正常の黄斑OCT画像

専門的なことだけど、網膜は10層構造でできているよ!
異常がある黄斑OCT画像

↑↑
視力低下や、ゆがみの自覚が出てくると手術による外科的な治療が必要になります。
また、稀に網膜の上の膜が自然とはずれることもあります。


↑↑
糖尿病や静脈閉塞症などでみられる黄斑浮腫は、注射による治療(硝子体内注射)を行う場合があります。


↑↑
強度近視は目の長さ(眼軸長)自体が長く、ラグビーボウルの形のように後ろに引き伸ばされているため、
OCT像がまっすぐではなく弓状になっている。
視神経OCT画像
主に緑内障の診断、進行しているかどうか定期的に撮影します。





視野検査とセットで行うことが多いよ!
検査を受けるときの注意点


- 散瞳検査(瞳を広げる検査)と併用されることがあり、その場合は検査後しばらくまぶしく、
車の運転ができません。 - 撮影中は目を動かさないように意識すると、より正確な画像が得られます。
- 白内障や角膜混濁など光の通り道が濁っている(透光体混濁)があると、十分な画像が撮影できない可能性があります。
関連記事:【散瞳検査(眼底)についてまとめています↓↓】


まとめ


OCT検査は、痛みもなく短時間で、目の奥をミクロレベルで観察できる検査です。
緑内障や加齢黄斑変性などの早期発見に欠かせない存在であり、
「見え方が少し変だな」「視界に影がある気がする」と感じたときには、
この検査を受けることで原因が見えてくるかもしれません。
関連記事:【眼科に行こうと決めたら、まずは持ち物をチェック!】


関連記事:【毎日の目のセルフケアに↓↓】








